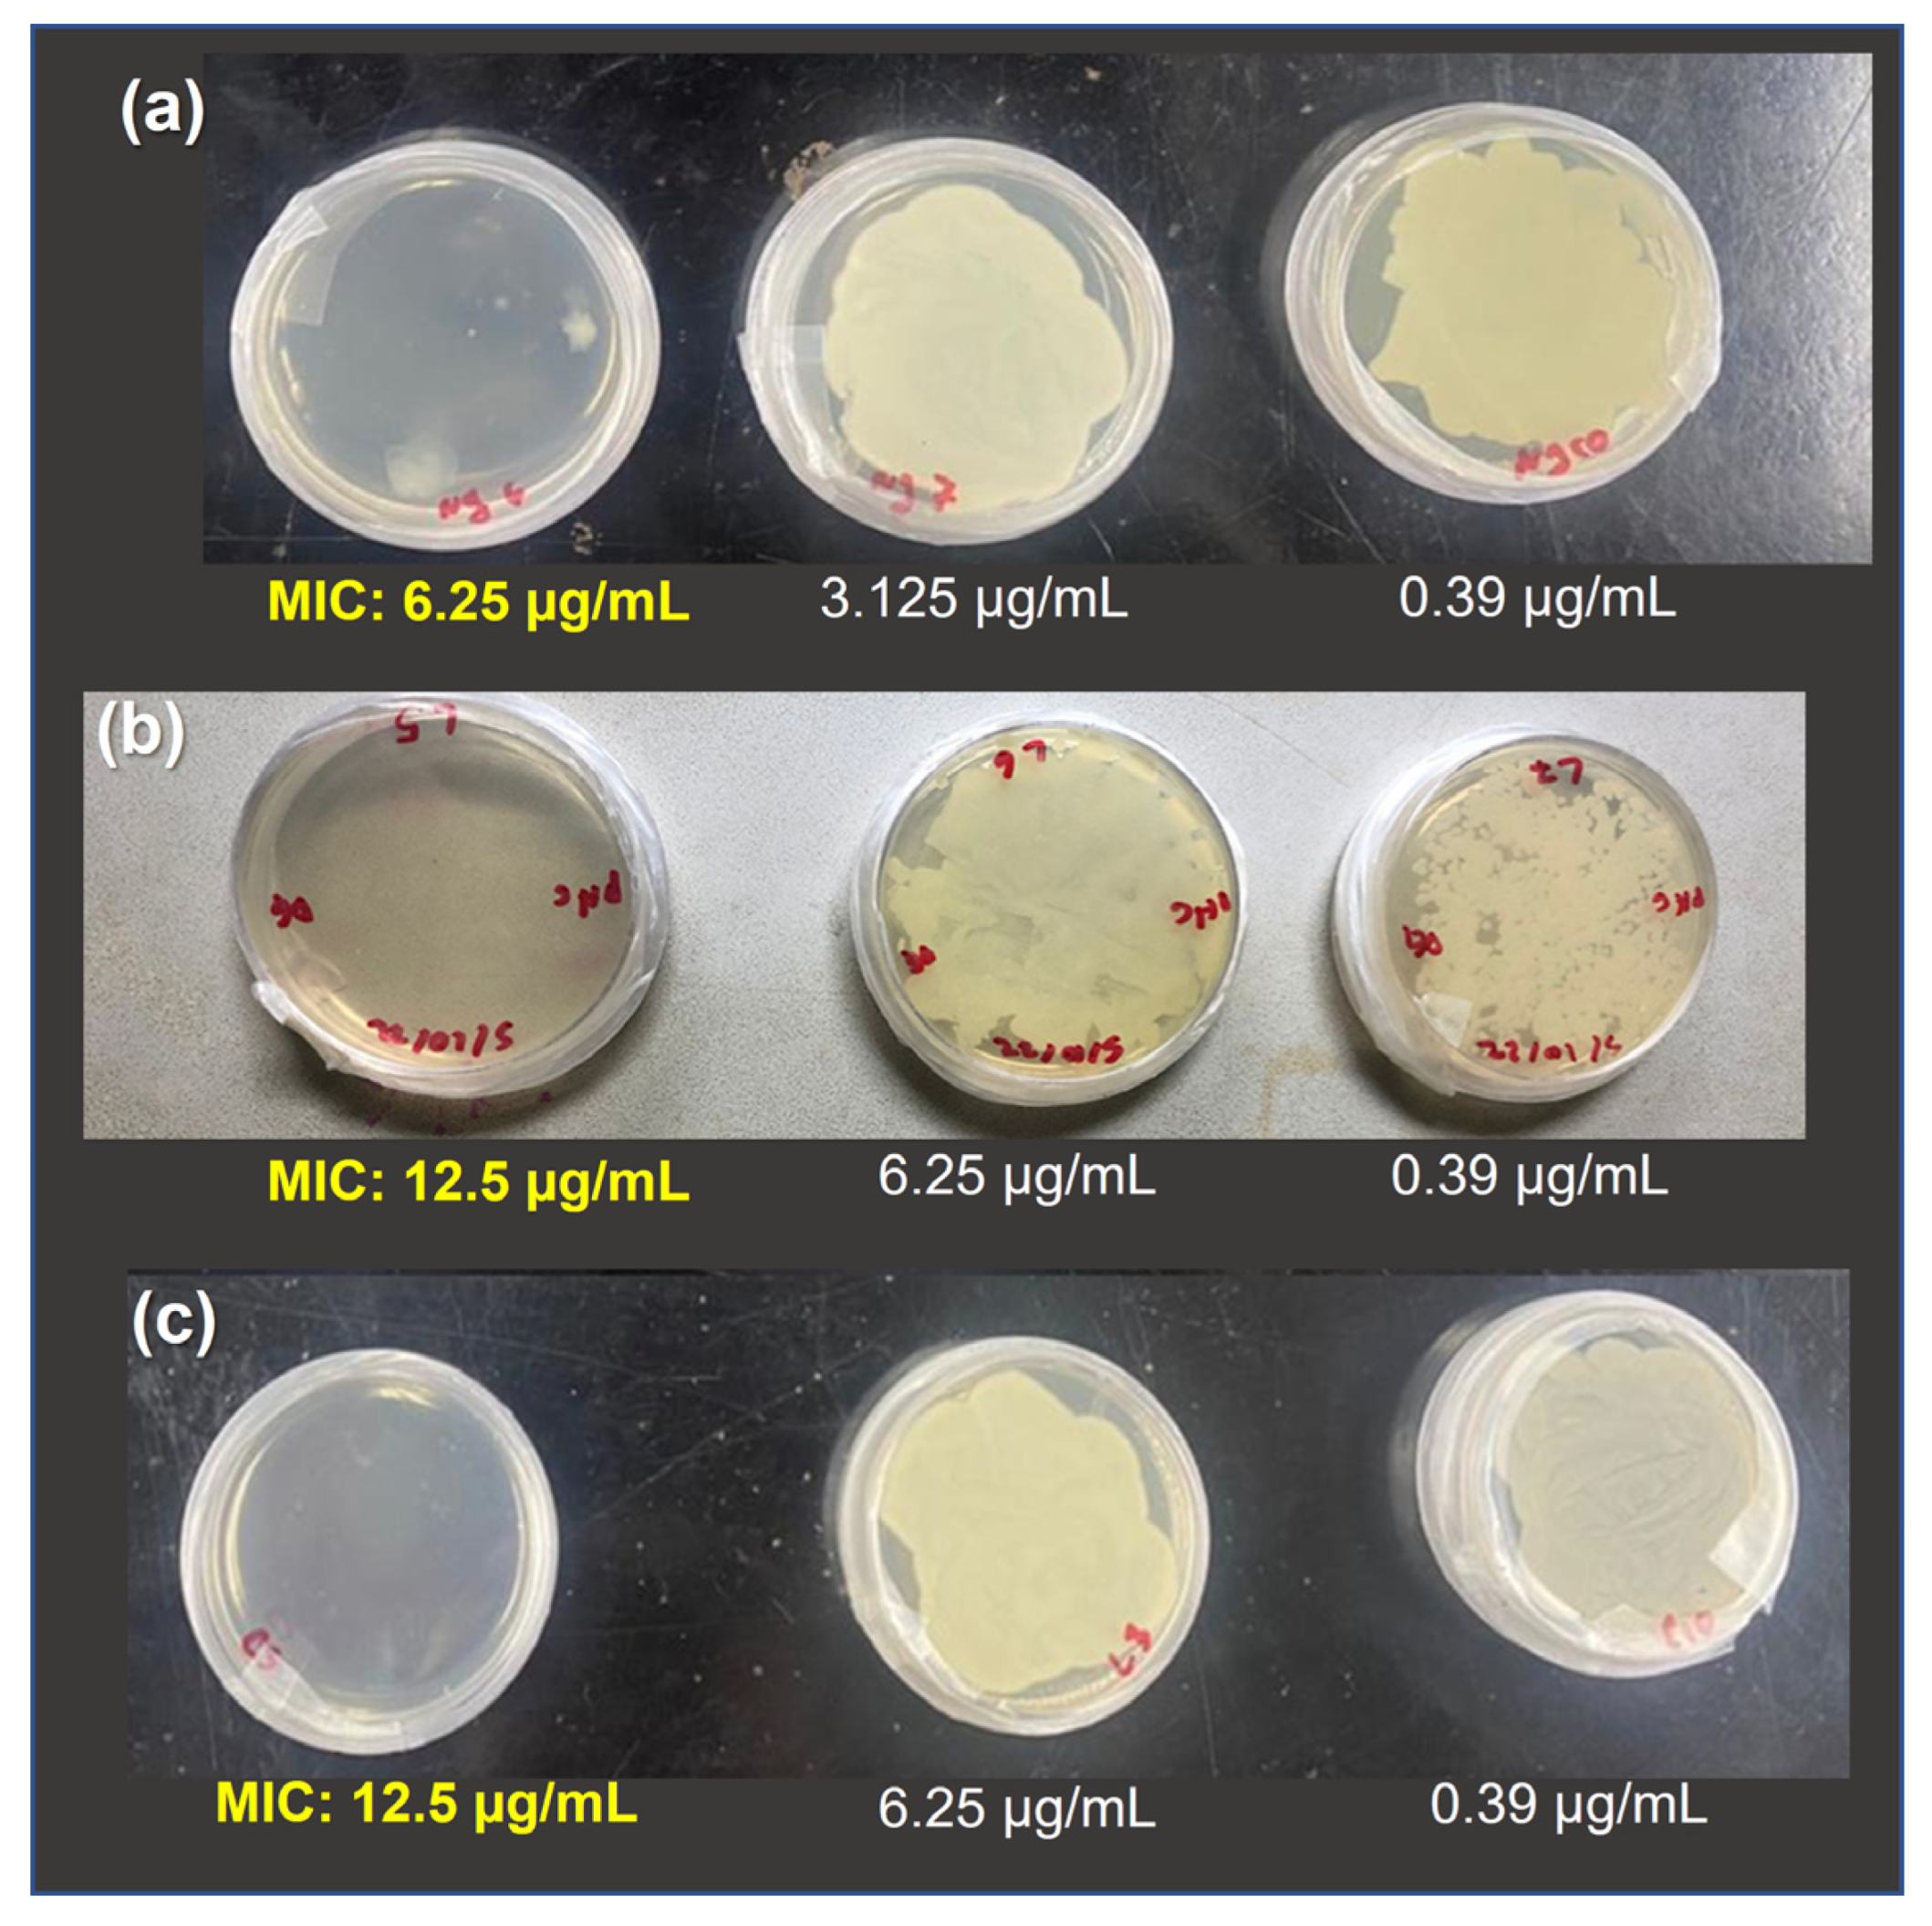
Polymers 15 04105 g006
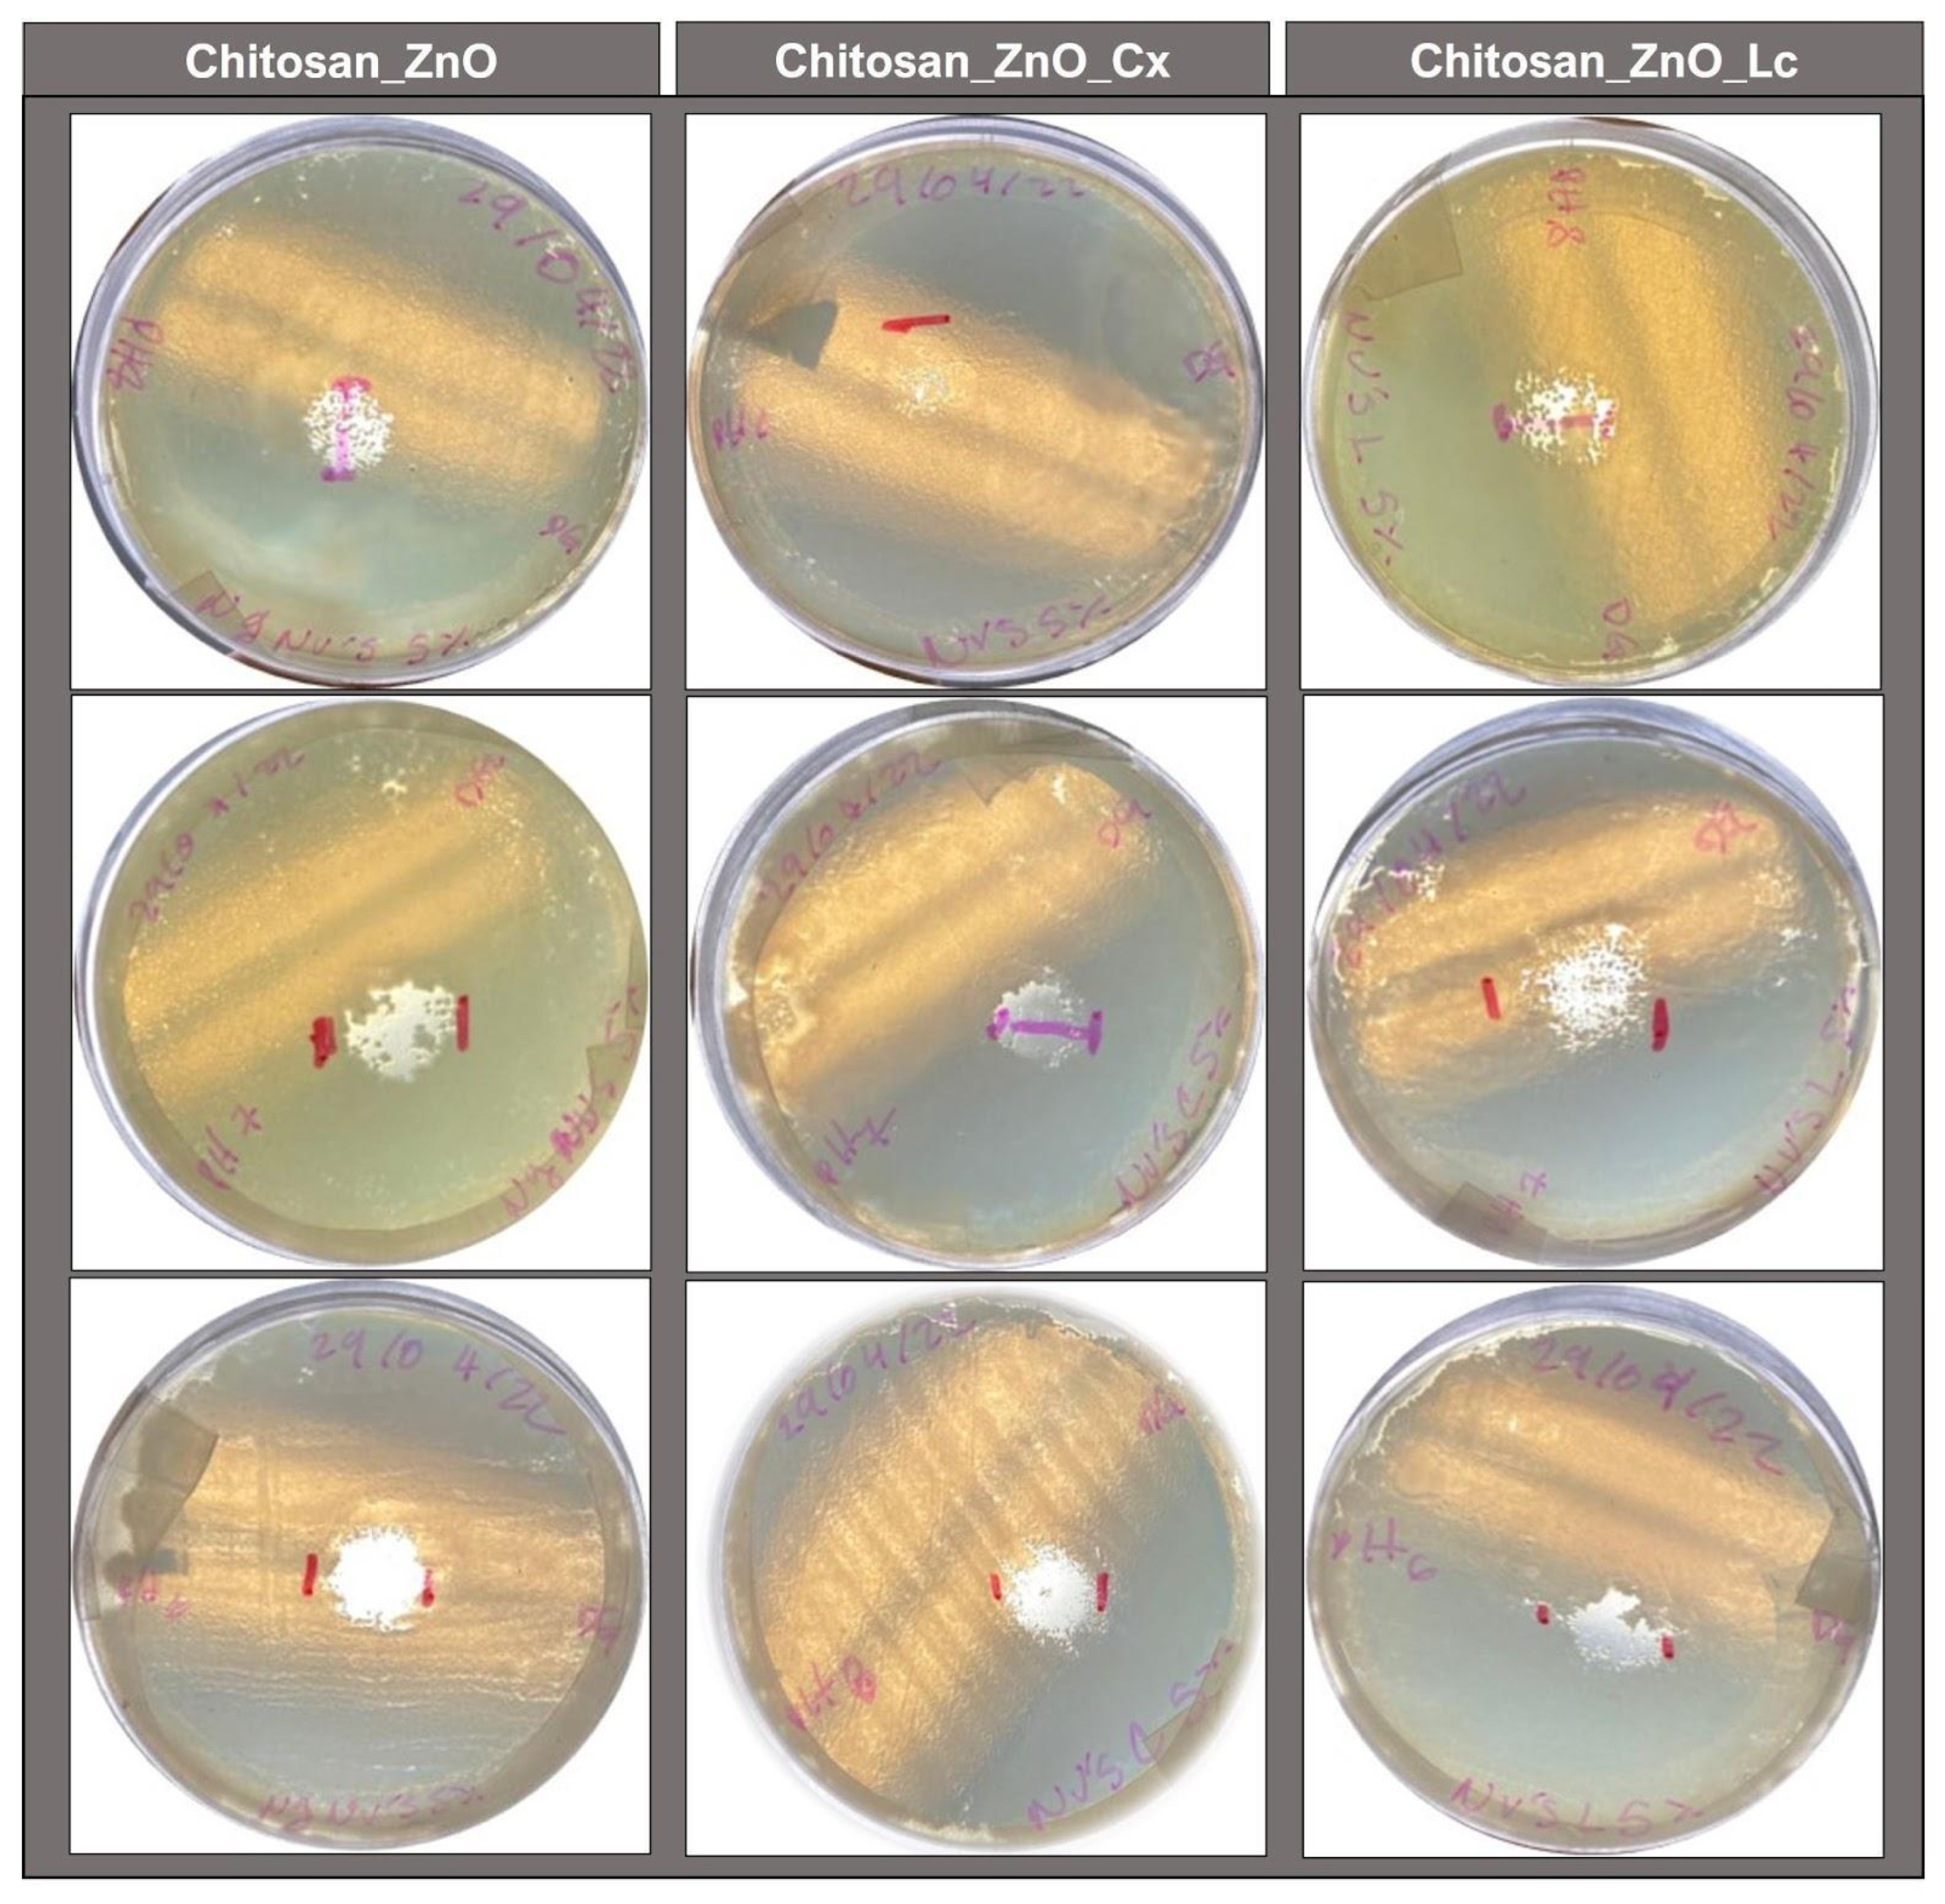
Polymers 15 04105 g007

pH-Responsive Chitosan-Doped ZnO Hybrid Hydrogels for the Encapsulation of Bioactive Compounds in Aquaculture
Abstract
:1. Introduction
2. Materials and Methods
2.1. AgCl-Doped ZnO Synthesis
2.2. Hydrogels Synthesis
2.2.1. Chitosan Hydrogels
2.2.2. Chitosan_ZnO Hybrid Hydrogels
2.3. Hydrogel Characterization
2.3.1. Morphology and Composition
2.3.2. Fourier Transformed Infrared (FT-IR) Spectroscopy
2.3.3. Swelling Behavior
2.4. Phytobiotic Hydrogel Loading
2.5. Hydrogel Antimicrobial Properties Evaluation
2.5.1. Antimicrobial Activity of the Synthesized Hydrogels
2.5.2. Minimum Inhibitory Concentration (MIC)
3. Results and Discussion
3.1. Morphology and Composition of Hydrogels
3.2. FT—IR
3.3. Swelling Behavior
3.4. Minimum Inhibitory Concentration (MIC)
3.5. Antimicrobial Activity of the Synthesized Hydrogels
4. Conclusions
Author Contributions
Funding
Institutional Review Board Statement
Data Availability Statement
Acknowledgments
Conflicts of Interest
References
- Naylor, R.L.; Hardy, R.W.; Buschmann, A.H.; Bush, S.R.; Cao, L.; Klinger, D.H.; Troell, M. A 20-year retrospective review of global aquaculture. Nature 2021, 591, 551–563. [Google Scholar] [CrossRef] [PubMed]
- FAO. El Estado Mundial de la Pesca y la Acuicultura 2022: Hacia la Transformación Azul; FAO: Rome, Italy, 2022. [Google Scholar] [CrossRef]
- Schar, D.; Klein, E.Y.; Laxminarayan, R.R.; Gilbert, M.; Van Boeckel, T.P. Global trends in antimicrobial use in aquaculture. Sci. Rep. 2020, 10, 21878. [Google Scholar] [CrossRef] [PubMed]
- Assefa, A.; Fufa, A. Maintenance of Fish Health in Aquaculture: Review of Epidemiological Approaches for Prevention and Control of Infectious Disease of Fish. Vet. Med. Int. 2018, 2018, 5432497. [Google Scholar] [CrossRef] [PubMed]
- Lulijwa, R.; Rupia, E.J.; Alfaro, A.C. Antibiotic use in aquaculture, policies and regulation, health and environmental risks: A review of the top 15 major producers. Rev. Aquacult. 2020, 12, 640–663. [Google Scholar] [CrossRef]
- Chen, J.; Sun, R.; Pan, C.; Sun, Y.; Mai, B.; Li, Q.X. Antibiotics and Food Safety in Aquaculture. J. Agric. Food Chem. 2020, 68, 11908–11919. [Google Scholar] [CrossRef]
- Chen, J.; Yang, Y.; Jiang, X.; Ke, Y.; He, T.; Xie, S. Metagenomic insights into the profile of antibiotic resistomes in sediments of aquaculture wastewater treatment system. J. Environ. Sci. 2021, 113, 345–355. [Google Scholar] [CrossRef]
- Pepi, M.; Focardi, S. Antibiotic-Resistant Bacteria in Aquaculture and Climate Change: A Challenge for Health in the Mediterranean Area. Int. J. Environ. Res. Public. Health 2021, 18, 5723. [Google Scholar] [CrossRef]
- Han, Q.F.; Zhao, S.; Zhang, X.R.; Wang, X.L.; Song, C.; Wang, S.G. Distribution, combined pollution and risk assessment of antibiotics in typical marine aquaculture farms surrounding the Yellow Sea, North China. Environ. Int. 2020, 138, 105551. [Google Scholar] [CrossRef]
- Thiang, E.L.; Lee, C.W.; Takada, H.; Seki, K.; Takei, A.; Suzuki, S.; Wang, A.; Bong, C.W. Antibiotic residues from aquaculture farms and their ecological risks in Southeast Asia: A case study from Malaysia. Ecosyst. Health Sustain. 2021, 7, 1926337. [Google Scholar] [CrossRef]
- Okeke, E.S.; Chukwudozie, K.I.; Nyaruaba, R.; Ita, R.E.; Oladipo, A.; Ejeromedoghene, O.; Okoye, C.O. Antibiotic resistance in aquaculture and aquatic organisms: A review of current nanotechnology applications for sustainable management. Environ. Sci. Pollut. Res. 2022, 29, 69241–69274. [Google Scholar] [CrossRef]
- Yin, Y.; Hu, B.; Yuan, X.; Cai, L.; Gao, H.; Yang, Q. Nanogel: A Versatile Nano-Delivery System for Biomedical Applications. Pharmaceutics 2020, 12, 290. [Google Scholar] [CrossRef] [PubMed]
- Bordbar-Khiabani, A.; Gasik, M. Smart Hydrogels for Advanced Drug Delivery Systems. Int. J. Mol. Sci. 2022, 23, 3665. [Google Scholar] [CrossRef] [PubMed]
- Wang, H.; Wang, B.; Wang, S.; Chen, J.; Zhi, W.; Guan, Y.; Zhu, X. Injectable in situ intelligent thermo-responsive hydrogel with glycyrrhetinic acid-conjugated nano graphene oxide for chemo-photothermal therapy of malignant hepatocellular tumor. J. Biomater. Appl. 2022, 37, 151–165. [Google Scholar] [CrossRef] [PubMed]
- Masoomi, D.; Gutierrez-Maddox, N.; Alfaro, A.; Seyfoddin, A. Encapsulation for delivering bioactives in aquaculture. Rev. Aquac. 2019, 11, 631–660. [Google Scholar] [CrossRef]
- Li, J.; Mooney, D. Designing hydrogels for controlled drug delivery. Nat. Rev. Mater. 2016, 1, 16071. [Google Scholar] [CrossRef]
- Sierra-Martin, B.; Fernandez-Barbero, A. Multifunctional hybrid nanogels for theranostic applications. Soft. Matter. 2015, 11, 8205–8216. [Google Scholar] [CrossRef]
- Mao-Hua, C.; Xiao-Yi, C.; Luo-Qin, F.; Wen-Lin, D.; Xue, Y.; Xiao-Zhou, M.; Pei-Yang, H. Design and Development of Hybrid Hydrogels for Biomedical Applications: Recent Trends in Anticancer Drug Delivery and Tissue Engineering. Front. Bioeng. Biotechnol. 2021, 9, 630943. [Google Scholar] [CrossRef]
- Nilsen-Nygaard, J.; Strand, S.P.; Vårum, K.M.; Draget, K.I.; Nordgård, C.T. Chitosan: Gels and Interfacial Properties. Polymers 2015, 7, 552–579. [Google Scholar] [CrossRef]
- Saeed, R.M.; Dmour, I.; Taha, M.O. Stable Chitosan-Based Nanoparticles Using Polyphosphoric Acid or Hexametaphosphate for Tandem Ionotropic/Covalent Crosslinking and Subsequent Investigation as Novel Vehicles for Drug Delivery. Front. Bioeng. Biotechnol. 2020, 8, 4. [Google Scholar] [CrossRef]
- Parhi, R. Drug delivery applications of chitin and chitosan: A review. Environ. Chem. Lett. 2020, 18, 577–594. [Google Scholar] [CrossRef]
- Yan, J.; Guo, C.; Dawood, M.A.O.; Gao, J. Effects of dietary chitosan on growth, lipid metabolism, immune response and antioxidant-related gene expression in Misgurnus anguillicaudatus. Benef. Microbes 2017, 8, 439–449. [Google Scholar] [CrossRef] [PubMed]
- FDA. CFR—Code of Federal Regulations Title 21, Chapter I, Subchapter A, Part 73, Subpart B. Available online: https://www.ecfr.gov/current/title-21 (accessed on 25 August 2023).
- Swain, P.S.; Rao, S.B.N.; Rajendran, D.; Dominic, G.; Selvaraju, S. Nano zinc, an alternative to conventional zinc as animal feed supplement: A review. Anim. Nutr. 2016, 2, 134–141. [Google Scholar] [CrossRef] [PubMed]
- Ifijen, I.H.; Maliki, M.; Anegbe, B. Synthesis, photocatalytic degradation and antibacterial properties of selenium or silver doped zinc oxide nanoparticles: A detailed review. OpenNano 2022, 8, 100082. [Google Scholar] [CrossRef]
- Yadav, S.; Sadique, M.A.; Pal, M.; Khan, R.; Srivastava, A.K. Cytotoxicity and DNA fragmentation-mediated apoptosis response of hexagonal ZnO nanorods against human prostate cancer cells. Appl. Surf. Sci. Adv. 2022, 9, 100237. [Google Scholar]
- Es-haghi, A.; Soltani, M.; Karimi, E.; Namvar, F.; Homayouni-Tabrizi, M. Evaluation of antioxidant and anticancer properties of zinc oxide nanoparticles synthesized using Aspergillus niger extract. Mater. Res. Express 2019, 6, 125415. [Google Scholar] [CrossRef]
- Nagajyothi, P.C.; Cha, S.J.; Yang, I.U.; Sreekanth, T.V.M.; Kim, K.J.; Shin, H.M. Antioxidant and anti-inflammatory activities of zinc oxide nanoparticles synthesized using Polygala tenuifolia root extract. J. Photochem. Photobiol. B Biol. 2015, 146, 10–17. [Google Scholar] [CrossRef]
- Li, Y.; Liao, C.; Tjong, S.C. Recent Advances in Zinc Oxide Nanostructures with Antimicrobial Activities. Int. J. Mol. Sci. 2020, 21, 8836. [Google Scholar] [CrossRef]
- Naskar, A.; Lee, S.; Kim, K. Antibacterial potential of Ni-doped zinc oxide nanostructure: Comparatively more effective against Gram-negative bacteria including multi-drug resistant strains. RSC Adv. 2020, 10, 1232–1242. [Google Scholar] [CrossRef]
- Muthusamy, C.; Ashokkumar, M.; Boopathyraja, A.; Priya, V.V. Enhanced ferro magnetism of (Cu, Fe/Mn) dual doped ZnO nanoparticles and assessment of in-vitro cytotoxicity and antimicrobial activity for magnetically guided immunotherapy and hyperthermia applications. Vacuum 2022, 205, 111400. [Google Scholar] [CrossRef]
- Ghadam, P.; Mohammadi, P.; Abdi Ali, A. Chapter 4—Silver-based nanoantimicrobials: Mechanisms, ecosafety, and future perspectives. In Silver Nanomaterials for Agri-Food Applications Nanobiotechnology for Plant Protection; Abd-Elsalam, K.A., Ed.; Elsevier: Amsterdam, The Netherlands, 2021; pp. 67–99. [Google Scholar] [CrossRef]
- Diaz Acosta, E. Nanopartículas de plata: Un enfoque en aplicaciones biológicas. Mundo Nano Rev. Interdiscip. En. Nanociencias Nanotecnol. 2018, 12, 1. [Google Scholar] [CrossRef]
- Gibała, A.; Żeliszewska, P.; Gosiewski, T.; Krawczyk, A.; Duraczyńska, D.; Szaleniec, J.; Szaleniec, M.; Oćwieja, M. Antibacterial and Antifungal Properties of Silver Nanoparticles-Effect of a Surface-Stabilizing Agent. Biomolecules 2021, 11, 1481. [Google Scholar] [CrossRef]
- Ullah, A.; Toufiq, A.M.; Qureshi, M.T.; Khan, A.; Younas, M.; Obeidat, S.T.; Elaimi, M.A.; Hameed, R.A.; Ullah, F. Hydrothermal synthesis, characterization and antimicrobial activity of Ag-modified ZnO nanoplates against pathogen. Dig. J. Nanomater. Biostruct. 2022, 17, 949–960. [Google Scholar] [CrossRef]
- Al-Enazi, N.M.; Alsamhary, K.; Kha, M.; Ameen, F. In Vitro anticancer and antibacterial performance of biosynthesized Ag and Ce co-doped ZnO NPs. Bioprocess. Biosyst. Eng. 2023, 46, 89–103. [Google Scholar] [CrossRef]
- Pradeev Raj, K.; Sadaiyandi, K.; Kennedy, A.; Sagadevan, S.; Chowdhury, Z.Z.; Johan, M.R.B.; Rathina Bala, R. Influence of Mg Doping on ZnO Nanoparticles for Enhanced Photocatalytic Evaluation and Antibacterial Analysis. Nanoscale Res. Lett. 2018, 13, 229. [Google Scholar] [CrossRef]
- Cardoza-Contreras, M.N.; Sánchez-Serrano, S.; Contreras, O.E. Highly Efficient photocatalytic and Antimicrobial AgGaCl Tri-Doped ZnO Nanorods for Water Treatment under Visible Light Irradiation. Catalysts 2020, 10, 752. [Google Scholar] [CrossRef]
- Cazarin, C.B.B.; Bicas, J.L.; Pastore, G.M.; Marostica Junior, M.R. Introduction. In Bioactive Food Components Activity in Mechanistic Approach; Baú Betim Cazarin, C., Lemos Bicas, J., Maria Pastore, G., Marostica, M.R., Jr., Eds.; Elsevier Academic Press: Cambridge, MA, USA, 2022; pp. 1–3. [Google Scholar] [CrossRef]
- Bajagai, Y.S.; Alsemgeest, J.; Moore, R.J.; Van, T.T.; Stanley, D. Phytogenic products, used as alternatives to antibiotic growth promoters, modify the intestinal microbiota derived from a range of production systems: An in vitro model. Appl. Microbiol. Biotechnol. 2020, 104, 10631–10640. [Google Scholar] [CrossRef] [PubMed]
- Magouz, F.I.; Mahmoud, S.A.; El-Morsy, R.A.; Paray, B.A.; Soliman, A.A.; Zaineldin, A.I.; Dawood, M.A. Dietary menthol essential oil enhanced the growth performance, digestive enzyme activity, immune-related genes, and resistance against acute ammonia exposure in Nile tilapia (Oreochromis niloticus). Aquaculture 2021, 530, 735944. [Google Scholar] [CrossRef]
- Nurudeen, N.D.; Ayisi, C.L.; Ampofo-Yeboah, A. Effects of Eucalyptus globulus leaf extract on growth performance, feed utilization and blood biochemistry of Nile tilapia, Oreochromis niloticus. Veterinaria 2022, 71, 175–189. [Google Scholar] [CrossRef]
- Ibrahim, D.; Shahin, S.E.; Alqahtani, L.S.; Hassan, Z.; Althobaiti, F.; Albogami, S.; Soliman, M.M.; El-Malt, R.M.S.; Al-Harthi, H.F.; Alqadri, N.; et al. Exploring the Interactive Effects of Thymol and Thymoquinone: Moving towards an Enhanced Performance, Gross Margin, Immunity and Aeromonas sobria Resistance of Nile Tilapia (Oreochromis niloticus). Animals 2022, 12, 3034. [Google Scholar] [CrossRef]
- Aanyu, M.; Betancor, M.B.; Monroig, O. Effects of dietary limonene and thymol on the growth and nutritional physiology of Nile tilapia (Oreochromis niloticus). Aquaculture 2018, 488, 217–226. [Google Scholar] [CrossRef]
- Nik Mohamad Nek Rahimi, N.; Natrah, I.; Loh, J.-Y.; Ervin Ranzil, F.K.; Gina, M.; Lim, S.-H.E.; Lai, K.-S.; Chong, C.-M. Phytocompounds as an Alternative Antimicrobial Approach in Aquaculture. Antibiotics 2022, 11, 469. [Google Scholar] [CrossRef]
- Caipang, C.M.A. Phytogenics in Aquaculture: A Short Review of Their Effects on Gut Health and Microflora in Fish. Philipp. J. Fish. 2020, 27, 246–259. [Google Scholar] [CrossRef]
- Yang, C.; Chowdhury, M.A.K.; Huo, Y.; Gong, J. Phytogenic Compounds as Alternatives to In-Feed Antibiotics: Potentials and Challenges in Application. Pathogens 2015, 4, 137–156. [Google Scholar] [CrossRef] [PubMed]
- Skwarczynska, A.; Kaminska, M.; Owczarz, P.; Bartoszek, N.; Walkowiak, B.; Modrzejewska, Z. The structural (FTIR, XRD, and XPS) and biological studies of thermosensitive chitosan chloride gels with β-glycerophosphate disodium. J. Appl. Polym. Sci. 2018, 135, 46459. [Google Scholar] [CrossRef]
- Silvestro, I.; Francolini, I.; Di Lisio, V.; Martinelli, A.; Pietrelli, L.; Scotto d’Abusco, A.; Scoppio, A.; Piozzi, A. Preparation and Characterization of TPP-Chitosan Crosslinked Scaffolds for Tissue Engineering. Materials 2020, 13, 3577. [Google Scholar] [CrossRef]
- Anand, M.; Sathyapriya, P.; Maruthupandy, M.; Hameedha, B.A. Synthesis of chitosan nanoparticles by TPP and their potential mosquito larvicidal application. Front. Lab. Med. 2018, 2, 72–78. [Google Scholar] [CrossRef]
- Martins, A.F.; Oliveira, M.; Pereira, A.; Rubira, A.F.; Muniz, E.C. Chitosan/TPP microparticles obtained by microemulsion method applied in controlled release of heparin. Int. J. Biol. Macromol. 2012, 51, 1127–1133. [Google Scholar] [CrossRef]
- Kavi Rajan, R.; Hussein, M.Z.; Fakurazi, S.; Yusoff, K.; Masarudin, M.J. Increased ROS Scavenging and Antioxidant Efficiency of Chlorogenic Acid Compound Delivered via a Chitosan Nanoparticulate System for Efficient In Vitro Visualization and Accumulation in Human Renal Adenocarcinoma Cells. Int. J. Mol. Sci. 2019, 20, 4667. [Google Scholar] [CrossRef]
- Fernandes Queiroz, M.; Melo, K.R.T.; Sabry, D.A.; Sassaki, G.L.; Rocha, H.A.O. Does the Use of Chitosan Contribute to Oxalate Kidney Stone Formation? Mar. Drugs 2015, 13, 141–158. [Google Scholar] [CrossRef]
- Salehizadeh, H.; Hekmatian, E.; Sadeghi, M.; Kennedy, K. Synthesis and characterization of core-shell Fe3O4-gold-chitosan nanostructure. J. Nanobiotechnol. 2012, 10, 3. [Google Scholar] [CrossRef]
- Varma, R.; Vasudevan, S. Extraction, Characterization, and Antimicrobial Activity of Chitosan from Horse Mussel Modiolus modiolus. ACS Omega 2020, 5, 20224–20230. [Google Scholar] [CrossRef]
- Ahammed, N.; Hassan, M.S.; Hassan, M. Effects of aluminum (Al) incorporation on structural, optical and thermal properties of ZnO nanoparticles. Mater. Sci. 2018, 36, 419–426. [Google Scholar] [CrossRef]
- Dahmane, E.M.; Taourirte, M.; Eladlani, N.; Rhazi, M. Extraction and characterization of chitin and chitosan from Parapenaeus longirostris from moroccan local sources. Int. J. Polym. Anal. Charact. 2014, 19, 342–351. [Google Scholar] [CrossRef]
- Ji, Y.; Yang, X.; Ji, Z.; Zhu, L.; Ma, N.; Chen, D.; Jia, X.; Tang, J.; Cao, Y. DFT-Calculated IR Spectrum Amide I, II, and III Band Contributions of N-Methylacetamide Fine Components. ACS Omega 2020, 5, 8572–8578. [Google Scholar] [CrossRef] [PubMed]
- Fischetti, T.; Celikkin, N.; Contessi, N.; Farè, S.; Swieszkowski, W. Tripolyphosphate-Crosslinked Chitosan/Gelatin Biocomposite Ink for 3D Printing of Uniaxial Scaffolds. Front. Bioeng. Biotechnol. 2020, 8, 400. [Google Scholar] [CrossRef]
- Liu, Y.; Shen, X.; Zhou, H.; Wang, Y.; Deng, L. Chemical modification of chitosan film via surface grafting of citric acid molecular to promote the biomineralization. Appl. Surf. Sci. 2016, 370, 270–278. [Google Scholar] [CrossRef]
- Mincke, S.; Asere, T.G.; Verheye, I.; Folens, K.; Bussche, F.V.; Lapeire, L.; Verbeken, K.; Voort, P.V.; Tessema, D.A.; Fufa, F.; et al. Functionalized chitosan adsorbents allow recovery of palladium and platinum from acidic aqueous solutions. Green Chem. 2019, 21, 2295–2306. [Google Scholar] [CrossRef]
- Khoerunnisa, F.; Nurhayati, M.; Dara, F.; Rizki, R.; Nasir, M.; Aziz, H.A.; Opaprakasit, P. Physicochemical Properties of TPP-Crosslinked Chitosan Nanoparticles as Potential Antibacterial Agents. Fibers Polym. 2021, 22, 2954–2964. [Google Scholar] [CrossRef]
- Bhumkar, D.R.; Pokharkar, V.B. Studies on Effect of pH on Cross-linking of Chitosan with Sodium Tripolyphosphate: A Technical Note. AAPS PharmSciTech 2006, 7, 50. [Google Scholar] [CrossRef]
- Qu, X.; Wirsén, A.; Albertsson, A.-C. Novel pH-sensitive chitosan hydrogels: Swelling behavior and states of water. Polymer 2000, 41, 4589–4598. [Google Scholar] [CrossRef]
- Borlongan, I.G.; Coloso, R.M.; Golez, N.V. Feeding habits and digestive physiology of fishes. In Nutrition in Tropical Aquaculture: Essentials of Fish Nutrition, Feeds, and Feeding of Tropical Aquatic Species; Millamena, O.M., Coloso, R.M., Pascual, F.P., Iloilo, T., Eds.; Aquaculture Department, Southeast Asian Fisheries Development Center: Manila, Philippines, 2002; pp. 77–97. Available online: http://hdl.handle.net/10862/3316 (accessed on 25 August 2023).
- Gilannejad, N.; Martínez-Rodríguez, G.; Yúfera, M.; Moyano, F.J. Modelling digestive hydrolysis of nutrients in fish using factorial designs and desirability function. PLoS ONE 2018, 13, e0206556. [Google Scholar] [CrossRef]
- Bakke, A.M.; Glover, C.; Krogdahl, A. 2—Feeding, digestion and absorption of nutrients. In Fish Physiology; Grosell, M., Farrell, A.P., Brauner, C.J., Eds.; Academic Press: London, UK, 2010; Volume 30, pp. 57–110. [Google Scholar] [CrossRef]
- Ouellette, R.J.; Rawn, D.J. 8—Alcohols and phenols. In Principles of Organic Chemistry; Robert, J., Ouellette, J., Rawn, D., Eds.; Elsevier: Amsterdam, The Netherlands, 2015; pp. 209–238. [Google Scholar] [CrossRef]

| Hydrogel | Inhibition Zones Diameters (cm) |
|---|---|
| Chitosan_ZnO | 1.53 ± 0.15 |
| Chitosan_ZnO_Lc | 1.43 ± 0.07 |
| Chitosan_ZnO_Cx | 0.83 ± 0.4 |
Disclaimer/Publisher’s Note: The statements, opinions and data contained in all publications are solely those of the individual author(s) and contributor(s) and not of MDPI and/or the editor(s). MDPI and/or the editor(s) disclaim responsibility for any injury to people or property resulting from any ideas, methods, instructions or products referred to in the content. |
© 2023 by the authors. Licensee MDPI, Basel, Switzerland. This article is an open access article distributed under the terms and conditions of the Creative Commons Attribution (CC BY) license (https://creativecommons.org/licenses/by/4.0/).
Share and Cite
Sánchez-Serrano, S.; González-Méndez, D.J.; Olivas-Valdez, J.A.; Millán-Aguiñaga, N.; Evangelista, V.; Contreras, O.E.; Cardoza-Contreras, M.N. pH-Responsive Chitosan-Doped ZnO Hybrid Hydrogels for the Encapsulation of Bioactive Compounds in Aquaculture. Polymers 2023, 15, 4105. https://doi.org/10.3390/polym15204105
Sánchez-Serrano S, González-Méndez DJ, Olivas-Valdez JA, Millán-Aguiñaga N, Evangelista V, Contreras OE, Cardoza-Contreras MN. pH-Responsive Chitosan-Doped ZnO Hybrid Hydrogels for the Encapsulation of Bioactive Compounds in Aquaculture. Polymers. 2023; 15(20):4105. https://doi.org/10.3390/polym15204105
Chicago/Turabian StyleSánchez-Serrano, Samuel, Daniela J. González-Méndez, José A. Olivas-Valdez, Natalie Millán-Aguiñaga, Viridiana Evangelista, Oscar E. Contreras, and Marlene N. Cardoza-Contreras. 2023. "pH-Responsive Chitosan-Doped ZnO Hybrid Hydrogels for the Encapsulation of Bioactive Compounds in Aquaculture" Polymers 15, no. 20: 4105. https://doi.org/10.3390/polym15204105
APA StyleSánchez-Serrano, S., González-Méndez, D. J., Olivas-Valdez, J. A., Millán-Aguiñaga, N., Evangelista, V., Contreras, O. E., & Cardoza-Contreras, M. N. (2023). pH-Responsive Chitosan-Doped ZnO Hybrid Hydrogels for the Encapsulation of Bioactive Compounds in Aquaculture. Polymers, 15(20), 4105. https://doi.org/10.3390/polym15204105
